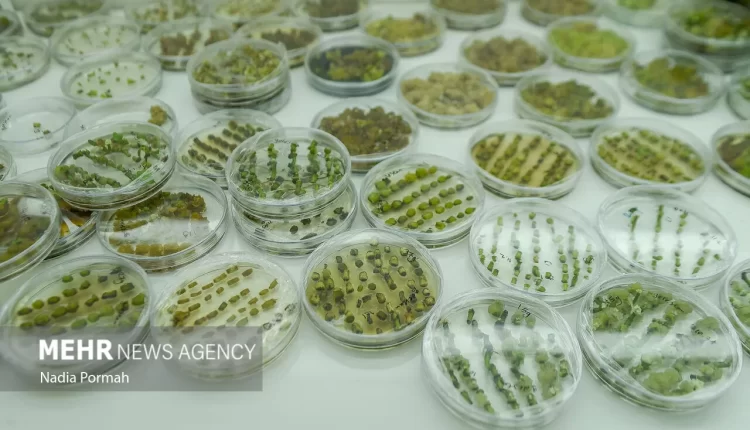

شرکتهای دانشبنیان تولیدکننده نهادههای کشاورزی حمایت میشوند
به گزارش خبرگزاری مهر، شمساله ملازاده، عضو هیأت مدیره و معاون فنی و کنترل کیفی شرکت خدمات حمایتی کشاورزی در نشست با نمایندگان شرکتهای دانشبنیان عضو انجمن صنفی تولید کنندگان فرآوردههای آلی و زیستی کشاورزی که با هدف گردآوری خواستهها و دغدغههای شرکتهای دانشبنیان فعال در حوزه تولید نهادههای کشاورزی به ویژه کود برگزار شد، گفت: شرکت خدمات حمایتی کشاورزی با توجه به اختیارات و امکانات در دسترس خود همواره آماده هرگونه همکاری با شرکتهای دانشبنیان فعال در زمینه تولید نهادههای کشاورزی است.
وی با بیان توضیحاتی در زمینه فرآیندهای فنی و تضمین کیفیت چرخه تأمین، تدارک و توزیع کودهای کشاورزی در این شرکت افزود: شرکتهای دانشبنیان میتوانند در قالب انعقاد تفاهمنامه، به صورت رایگان از شبکه توزیع گستره این شرکت در سراسر کشور (بیش از ۳۵۰۰ کارگزاری) برای معرفی و فروش محصولات کودی تولیدی خود استفاده کنند.
وی ادامه داد: این شرکتها میتوانند در نمایشگاهها و همایشهایی که توسط شرکت خدمات حمایتی کشاورزی در تمام استانها برگزار میشود، حضور یافته و نسبت به معرفی محصولات تولیدی خود به کارگزاران توزیع نهادههای کشاورزی و کشاورزان زبده و کارشناسان ترویج، اقدام کنند.
نمایندگان انجمن صنفی تولیدکنندگان فرآوردههای آلی و زیستی کشاورزی در این نشست، ضمن برشمردن اهمیت همکاری در حفظ و توسعه ظرفیتهای صادراتی محصولات کودی شرکتهای دانشبنیان، بر ضرورت بهرهبرداری از ظرفیت توسعه مصرف داخلی محصولات کودی این شرکتها در طرحهای جامع بخش کشاورزی تاکید کردند.
همچنین اعضای این انجمن ضمن تاکید بر ضرورت همکاری وزارت جهاد کشاورزی و شرکت خدمات حمایتی کشاورزی در زمینه تجاریسازی محصولات کودی دانشبنیان تولید شده در شرکتهای دانشبنیان، رعایت دستورالعملها، ضوابط و پروتکلهای رایج تجاریسازی در ارتباط با محصولات کودی شرکتهای مزبور بویژه در مؤسسه تحقیقات خاک و آب، را خواستار شدند.